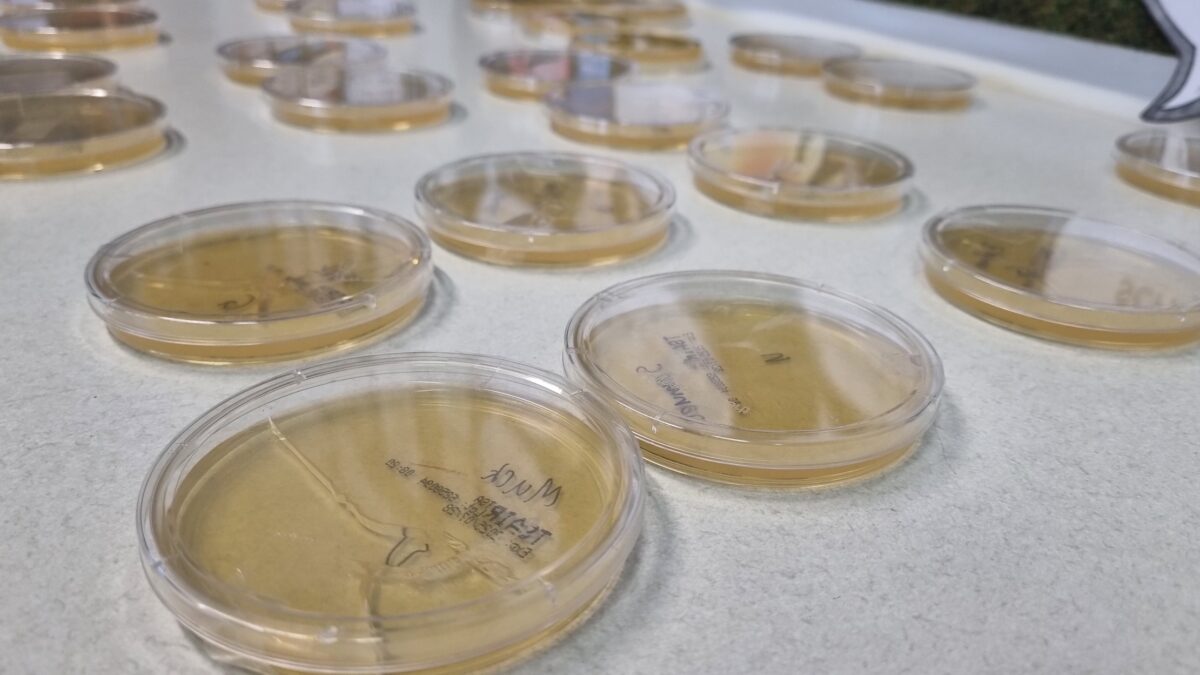

Neusorger Grundschüler lernen Körperhygiene spielerisch

Neusorger Grundschüler lernen Körperhygiene spielerisch
In der Fichtelnaabtalschule in Neusorg war letzte Woche einiges los. Die dritten Klassen hatten Besuch von Rebekka Thöns, einer Apothekerin am Universitätsklinikum Regensburg. Sie hielt einen lebendigen Vortrag über Körperhygiene und Hautschutz. Thöns teilte ihr umfangreiches Fachwissen auf eine Weise, die für die Kinder leicht verständlich war.
Haut als Schutzorgan
Den Schülerinnen und Schülern wurde erklärt, welch zentrale Rolle die Haut für unseren Körper spielt. Sie dient als Schutzorgan, das uns umhüllt und wichtige Körperteile und Funktionen bewahrt. Die Haut ist wie ein Haus, das unseren Körper umgibt und dafür sorgt, dass alles Wichtige im Inneren geschützt bleibt, beschreibt Thöns die Funktion der Haut. Besonders betont wurde, wie entscheidend Händewaschen im Kampf gegen Krankheiten ist. Es sei mehr als nur eine Routine; es sei ein essenzieller Schutz.
Praktische Experimente
Ein Highlight des Vormittags war sicherlich das Experiment mit Sedimentationsplatten. Die Kinder durften ihren Fingerabdruck auf Nährböden hinterlassen – und zwar einmal vor und einmal nach dem Händewaschen. Diese Platten werden in den kommenden Tagen in der Schule beobachtet. Die Kinder können so das Wachstum von Bakterien verfolgen und lernen, wie wirkungsvoll gute Hygienepraktiken sind.
Hautpflege hautnah
Auch die praktische Seite kam nicht zu kurz. Verschiedene Hautcremes wurden vorgestellt und auf ihre Wirkung hin untersucht. Die Kinder erhielten die Möglichkeit, selbst zu testen und zu erfahren, wie sich gepflegte Haut anfühlt. Mit viel anschaulichem Wissen und praktischen Übungen hat Frau Thöns bei den Kindern sowohl Neugier als auch ein Bewusstsein für ihren eigenen Körper geweckt.
Dieser Vormittag bot eine Kombination aus Theorie und Praxis, die den Kindern die Bedeutung von Körperhygiene und Hautschutz auf eine einprägsame Weise näher brachte. Ein Erlebnis, das mit Sicherheit noch lange in Erinnerung bleiben wird.